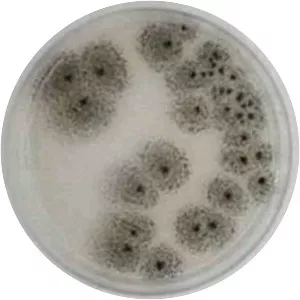
Aspergillus awamori -

Aspergillus Luchuensis
| Use attributes for filter ! | |
| Rank | Species |
|---|---|
| Higher classification | Aspergillus |
| Date of Reg. | |
| Date of Upd. | |
| ID | 3132820 |
About Aspergillus Luchuensis
Aspergillus luchuensis is a species of fungus in the genus Aspergillus. It belongs to the group of black Aspergilli which are important industrial workhorses. A. luchuensis belongs to the Nigri section. It has been used to produce awamori, a distilled alcoholic beverage made on the Okinawa islands in Japan.